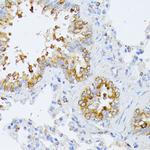
eIF2b beta Antibody in Immunohistochemistry (Paraffin) (IHC (P))

Search
Invitrogen
eIF2b beta Polyclonal Antibody
{{$productOrderCtrl.translations['antibody.pdp.commerceCard.promotion.promotions']}}
{{$productOrderCtrl.translations['antibody.pdp.commerceCard.promotion.viewpromo']}}
{{$productOrderCtrl.translations['antibody.pdp.commerceCard.promotion.promocode']}}: {{promo.promoCode}} {{promo.promoTitle}} {{promo.promoDescription}}. {{$productOrderCtrl.translations['antibody.pdp.commerceCard.promotion.learnmore']}}
产品信息
PA5-96551
种属反应
宿主/亚型
分类
类型
抗原
偶联物
形式
浓度
规格
纯化类型
保存液
内含物
保存条件
运输条件
RRID
产品详细信息
Immunogen sequence: MPGSAAKGSE LSERIESFVE TLKRGGGPRS SEEMARETLG LLRQIITDHR WSNAGELMEL IRREGRRMTA AQPSETTVGN MVRRVLKIIR EEYGRLHGRS DESDQQESLH KLLTSGGLNE
Positive Samples: Mouse thymus, Rat kidney
靶标信息
eIF2b beta is the beta subunit of eukaryotic initiation factor-2B (EIF2B). EIF2B is involved in protein synthesis and exchanges GDP and GTP for its activation and deactivation.
仅用于科研。不用于诊断过程。未经明确授权不得转售。
篇参考文献 (0)
生物信息学
蛋白别名: eIF-2B GDP-GTP exchange factor subunit beta; eIF2B GDP-GTP exchange factor subunit beta; eukaryotic translation initiation factor 2B, subunit 2 (beta, 39kD); eukaryotic translation initiation factor 2B, subunit 2 beta, 39kDa; ORF; putative; S20I15; S20III15; similar to translation initiation factor eIF-2B beta subunit; translation initiation factor eIF-2B subunit beta; Translation initiation factor eIF2B subunit beta; unnamed protein product
基因别名: AA409345; C85417; EIF-2Bbeta; EIF2B; EIF2B2; EIF2BB; EIF2Bbeta; VWM2
UniProt ID: (Human) P49770, (Mouse) Q99LD9
Entrez Gene ID: (Human) 8892, (Mouse) 217715, (Rat) 84005